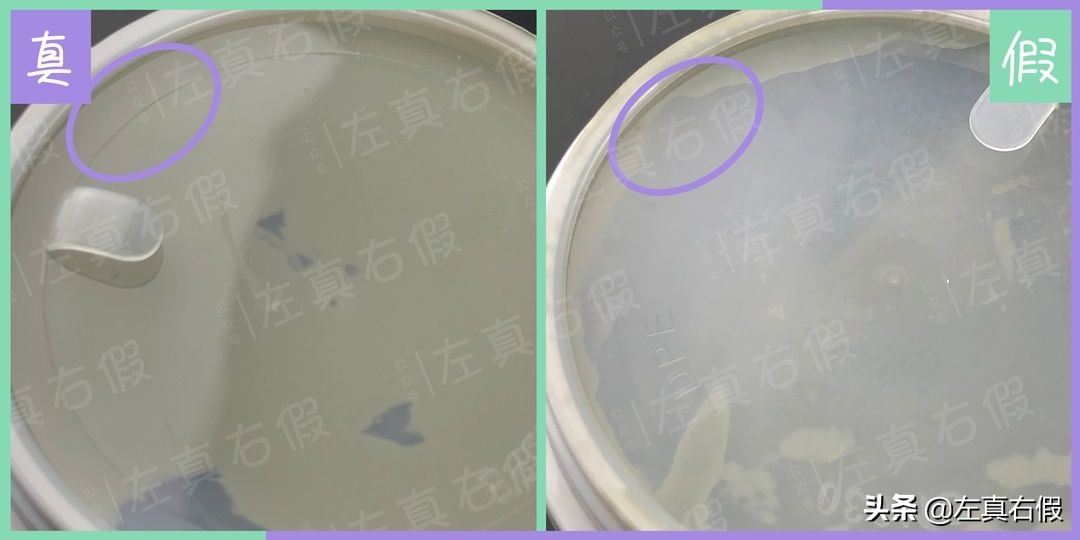
火山泥膜美白保湿面膜,火山泥清洁面膜老牌

所有泥状清洁面膜最大的共同点就是干、紧绷
敷到后面好像跟墙皮掉下来一样,脸崩的难受

经典如科颜氏白泥面膜
也避免不了拔干和微刺痛的肤感
但今天这款清洁面膜可以说是颠覆我的认知了

geoskincare纽西之谜火山岩泥毛孔紧实面膜
是连干皮都很适合的清洁面膜
洗干净之后脸蛋还很湿润的,也就这个了
完全不会干!完全不会紧绷!是完全不!
光从使用感来说可以给满分不怕它骄傲

它含有圣托尼瓦火山泥成分
能够吸附脸上的污垢
一打开感觉有一股矿物质的味道
膏体就是矿物质火山泥的质地
有很强的吸附力

质地很水润,而且不刺激
我是一个容易清洁不干净就长闭口的人
一周用两次清洁面膜,闭口粉刺基本不长了

敷完洗干净之后黑头白头都慢慢冒出来了
可以用吸黑头仪吸了一下
之后敷上补水面膜

在出油多的t区敷了一下
毛孔也是肉眼可见的缩小了
清洁度很满意

而且价格好便宜
90多块钱一大罐
所以请厚敷,效果更好!
推荐!
NOTICE
以下对比仅基于个人看法及相关了解
不排除个别鉴别点存在版本差异
仅限此版本对比,其他版本仅供参考
请综合多个辨别点进行对比
文章实用期为3~4个月,过后请等待更新


上周刚写完纽西之谜的妆前乳
清洁面膜又来了
其实首图就能看出色差
假货的颜色偏绿了



正品字母“e”的“尾巴”较短
假货的“尾巴”要长一些
纵向上基本和“头部”右侧持平了

假货“雪山”图案印刷不够清楚


正品背面的“℃”符号的“○”
比较瘦长,和旁边的数字0差不多
假货的则是规则的正圆


到了瓶身上“e”又出了问题
正品是带有一层黑色细描边的
假货就是普通的样式


正品螺纹断开距离较窄
长度基本和螺纹粗细差不多了
假货断开的距离长很多
长度大概有螺纹粗细的2倍吧

正品密封盖又一圈明显的模具线
假货其实也有但非常浅
我都拍不出来……

正品密封盖上突起的文字
也是比较窄瘦的字体
假货嘛就要丰满很多了

正品的密封盖不透明
所以圈出来的位置看不到背后的图案
假货则是带有一定透明度的
可以依稀看到背后图案的轮廓与颜色


正品比较厚重
质地挺括密实,非常顺滑
假货要稀很多
有一点黏黏的胶感和透明感
